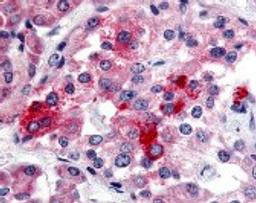

Product & ReviewsAntibodies
BRS3 Antibody
Product Details
- Cat. No.
- 48-152
- Type
- Primary Antibody
- Clonality
- Polyclonal
- Host
- Rat

The supplier does not provide quotations for this antibody through SelectScience. You can search for similar antibodies in our Antibody Directory.
Description
BRS3 Antibody raised in Rabbit validated in IHC in Gibbon, Gorilla, Human.
Biological Information
- Clonality: Polyclonal
- Host: Rat
- Conjugate: Unconjugated
Handling
- Quantity: 0.05 mg
- Storage: BRS3 antibody should be stored long term (months) at -80 ˚C and short term (days) at 4 ˚C. As with all antibodies avoid freeze/thaw cycles.
- Buffer: PBS, 0.1% sodium azide.